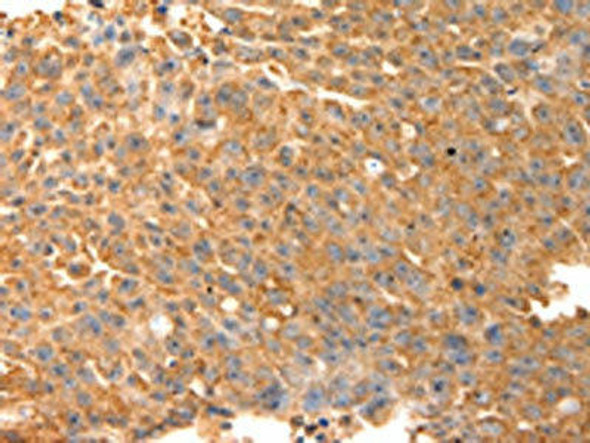
SPATA2L Antibody (PACO15060)

Antibodies
- Product
- Qty in Cart
- Quantity
- Price
- Subtotal
-

TEKT3 Antibody (PACO15109)
// system_update_altDatasheetsystem_update_altMSDSOverviewAntibody Name:TEKT3 Antibody (PACO15109)Antibody SKU:PACO15109Size:50ulHost Species:RabbitTested Applications:ELISA, WBRecommended Dilutions:ELISA:1:1000-1:2000, WB:1:200-1:1000Species...Qty in Cart: 0Price:Subtotal: -

SPATA17 Antibody (PACO15064)
// system_update_altDatasheetsystem_update_altMSDSOverviewAntibody Name:SPATA17 Antibody (PACO15064)Antibody SKU:PACO15064Size:50ulHost Species:RabbitTested Applications:ELISA, WB, IHCRecommended Dilutions:ELISA:1:1000-1:5000, WB:1:200-1:1000,...Qty in Cart: 0Price:Subtotal: -

SPATA17 Antibody (PACO15063)
// system_update_altDatasheetsystem_update_altMSDSOverviewAntibody Name:SPATA17 Antibody (PACO15063)Antibody SKU:PACO15063Size:50ulHost Species:RabbitTested Applications:ELISA, WB, IHCRecommended Dilutions:ELISA:1:1000-1:5000, WB:1:200-1:1000,...Qty in Cart: 0Price:Subtotal: -
SPATA2L Antibody (PACO15060)
// system_update_altDatasheetsystem_update_altMSDSOverviewAntibody Name:SPATA2L Antibody (PACO15060)Antibody SKU:PACO15060Size:50ulHost Species:RabbitTested Applications:ELISA, WB, IHCRecommended Dilutions:ELISA:1:2000-1:5000, WB:1:200-1:1000,...Qty in Cart: 0Price:Subtotal: -

SPATA2L Antibody (PACO15059)
// system_update_altDatasheetsystem_update_altMSDSOverviewAntibody Name:SPATA2L Antibody (PACO15059)Antibody SKU:PACO15059Size:50ulHost Species:RabbitTested Applications:ELISA, WB, IHCRecommended Dilutions:ELISA:1:2000-1:5000, WB:1:500-1:2000,...Qty in Cart: 0Price:Subtotal: -

SPATA13 Antibody (PACO15058)
// system_update_altDatasheetsystem_update_altMSDSOverviewAntibody Name:SPATA13 Antibody (PACO15058)Antibody SKU:PACO15058Size:50ulHost Species:RabbitTested Applications:ELISA, WB, IHCRecommended Dilutions:ELISA:1:1000-1:2000, WB:1:200-1:1000,...Qty in Cart: 0Price:Subtotal: -

SPATA13 Antibody (PACO15057)
// system_update_altDatasheetsystem_update_altMSDSOverviewAntibody Name:SPATA13 Antibody (PACO15057)Antibody SKU:PACO15057Size:50ulHost Species:RabbitTested Applications:ELISA, WB, IHCRecommended Dilutions:ELISA:1:1000-1:2000, WB:1:200-1:1000,...Qty in Cart: 0Price:Subtotal: -

SPDL1 Antibody (PACO15039)
// system_update_altDatasheetsystem_update_altMSDSOverviewAntibody Name:SPDL1 Antibody (PACO15039)Antibody SKU:PACO15039Size:50ulHost Species:RabbitTested Applications:ELISA, WBRecommended Dilutions:ELISA:1:1000-1:2000, WB:1:200-1:1000Species...Qty in Cart: 0Price:Subtotal: -

SPDL1 Antibody (PACO15038)
// system_update_altDatasheetsystem_update_altMSDSOverviewAntibody Name:SPDL1 Antibody (PACO15038)Antibody SKU:PACO15038Size:50ulHost Species:RabbitTested Applications:ELISA, WBRecommended Dilutions:ELISA:1:2000-1:5000, WB:1:500-1:2000Species...Qty in Cart: 0Price:Subtotal: -

SPIN4 Antibody (PACO15035)
// system_update_altDatasheetsystem_update_altMSDSOverviewAntibody Name:SPIN4 Antibody (PACO15035)Antibody SKU:PACO15035Size:50ulHost Species:RabbitTested Applications:ELISA, WB, IHCRecommended Dilutions:ELISA:1:1000-1:2000, WB:1:200-1:1000,...Qty in Cart: 0Price:Subtotal: -

SLC19A2 Antibody (PACO14998)
// system_update_altDatasheetsystem_update_altMSDSOverviewAntibody Name:SLC19A2 Antibody (PACO14998)Antibody SKU:PACO14998Size:50ulHost Species:RabbitTested Applications:ELISA, IHCRecommended Dilutions:ELISA:1:1000-1:2000, IHC:1:15-1:50Species...Qty in Cart: 0Price:Subtotal: -

SLC12A4 Antibody (PACO14997)
// system_update_altDatasheetsystem_update_altMSDSOverviewAntibody Name:SLC12A4 Antibody (PACO14997)Antibody SKU:PACO14997Size:50ulHost Species:RabbitTested Applications:ELISA, IHCRecommended Dilutions:ELISA:1:2000-1:5000, IHC:1:50-1:200Species...Qty in Cart: 0Price:Subtotal:
